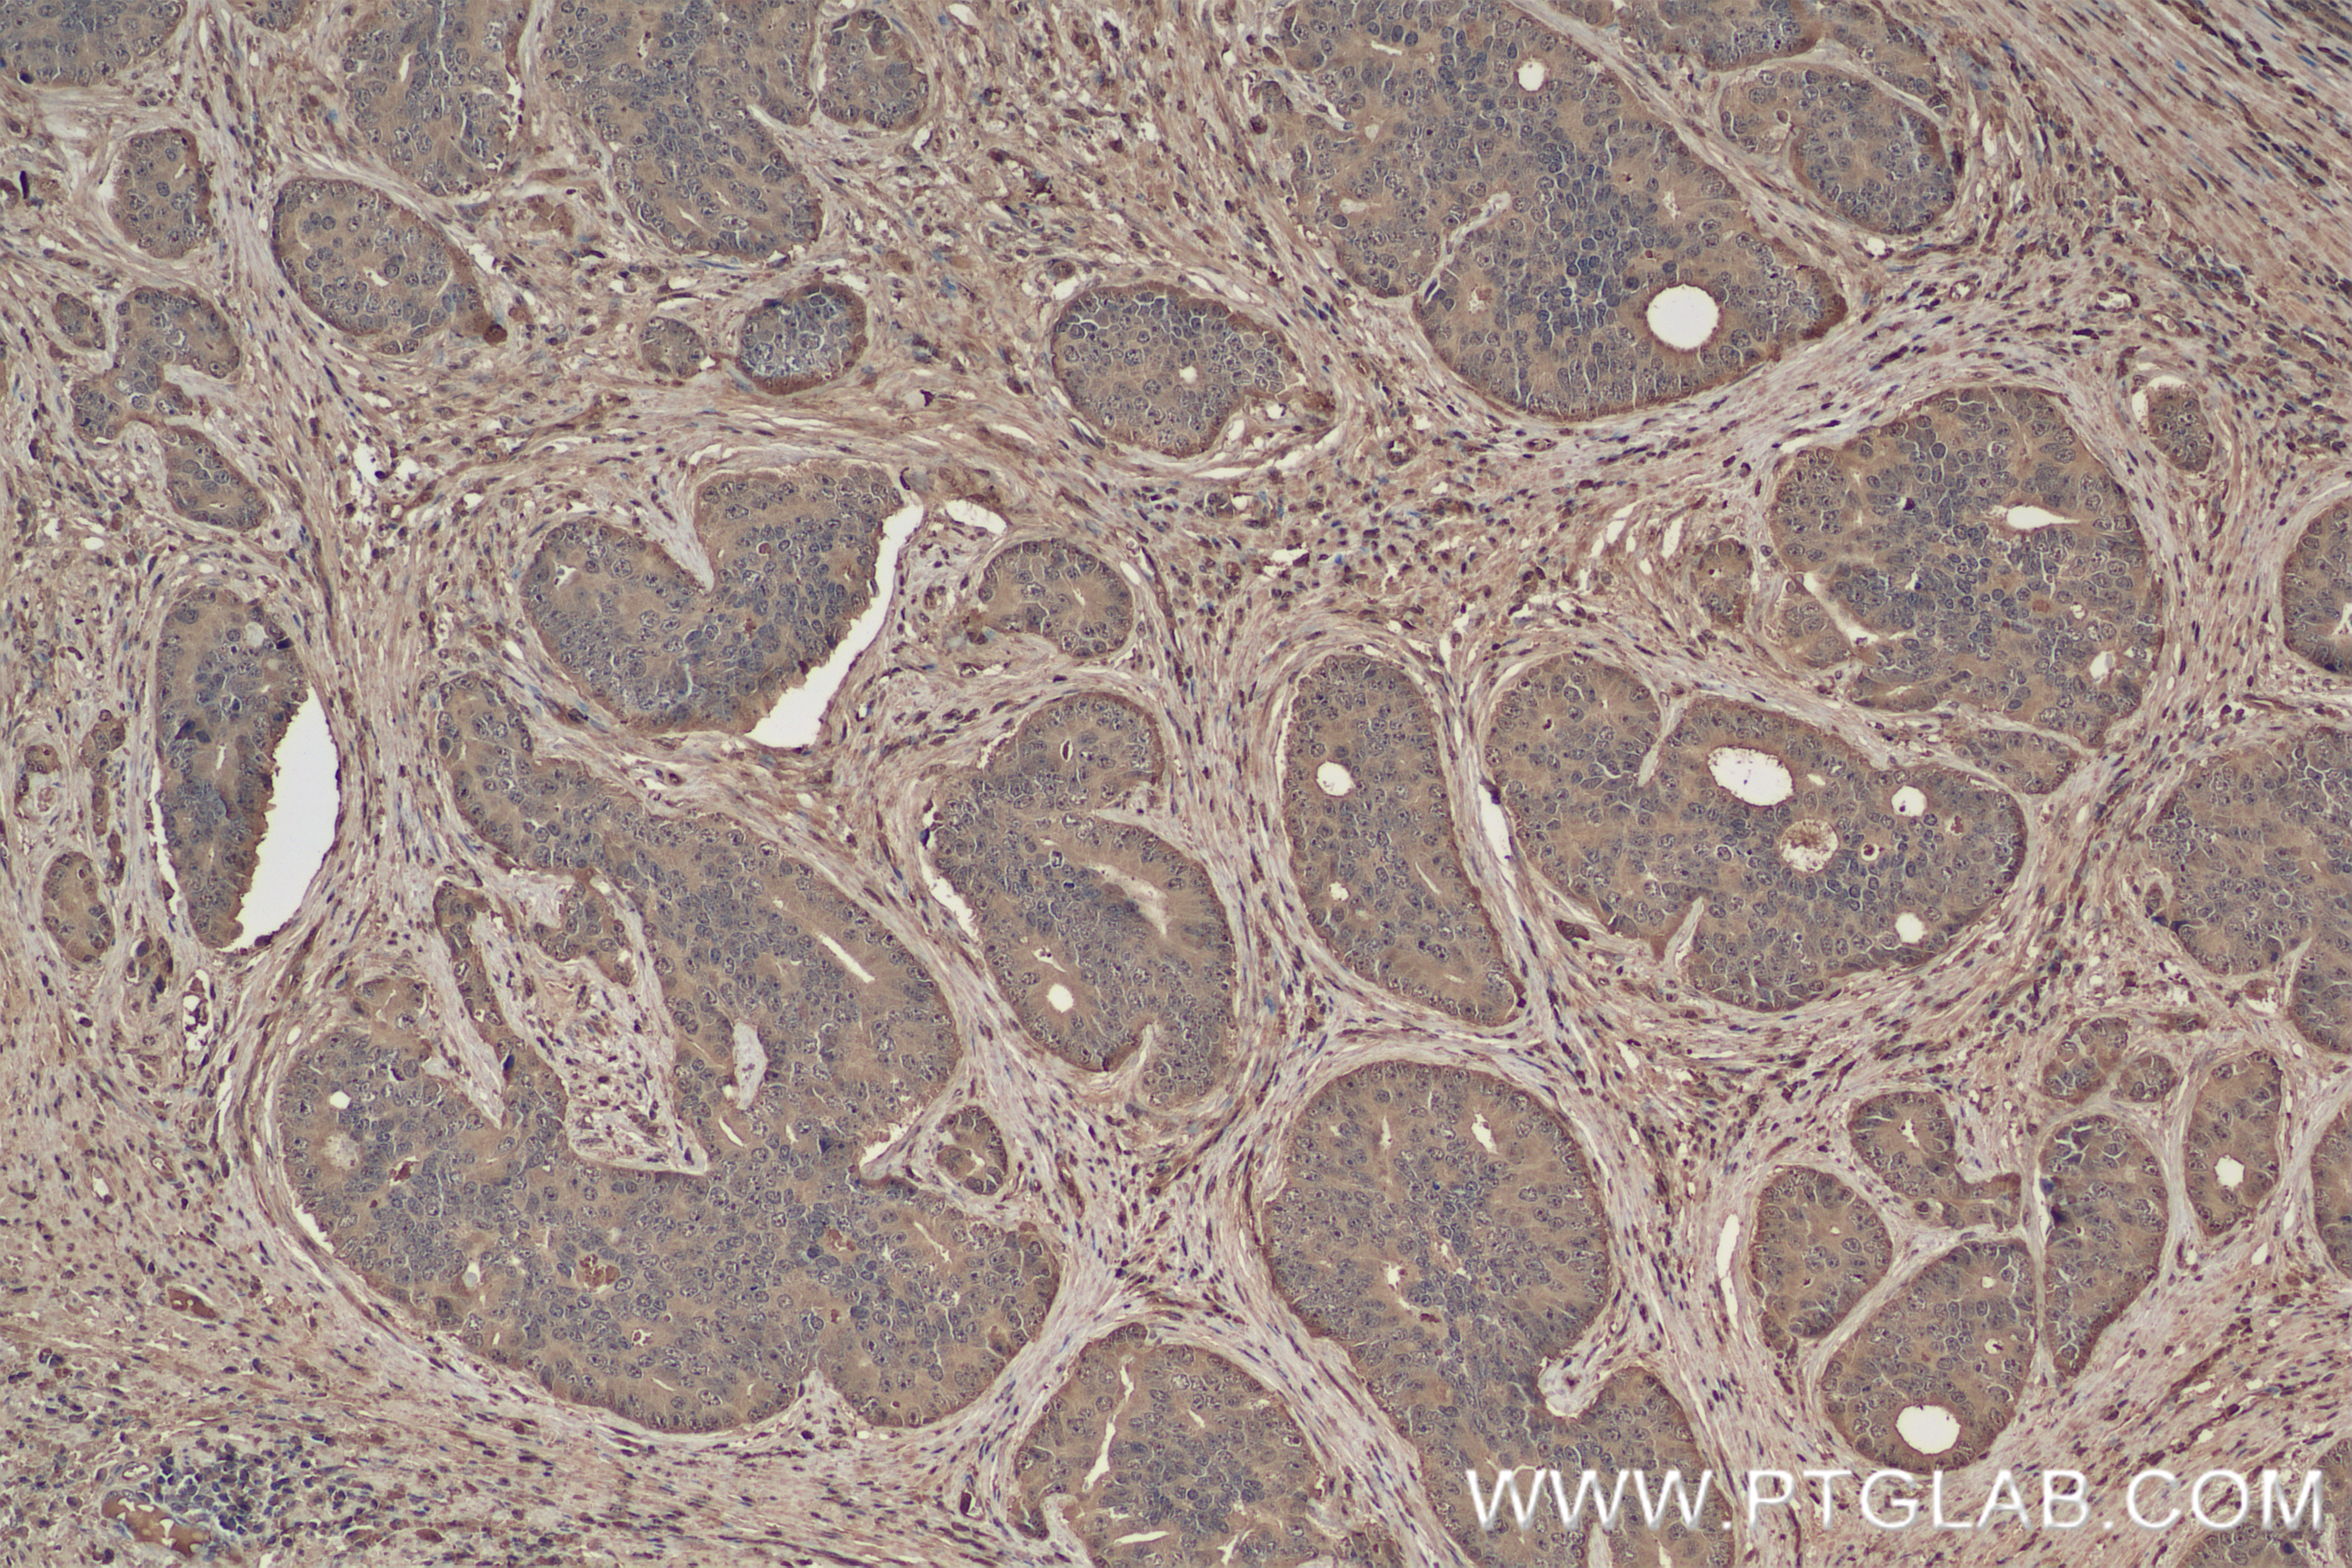

验证数据展示
经过测试的应用
| Positive WB detected in | HepG2 cells, HEK-293 cells |
| Positive IHC detected in | mouse testis tissue, human prostate cancer tissue, mouse brain tissue, rat liver tissue Note: suggested antigen retrieval with TE buffer pH 9.0; (*) Alternatively, antigen retrieval may be performed with citrate buffer pH 6.0 |
| Positive IF/ICC detected in | HeLa cells |
| Positive FC (Intra) detected in | U-2 OS |
推荐稀释比
| 应用 | 推荐稀释比 |
|---|---|
| Western Blot (WB) | WB : 1:1000-1:6000 |
| Immunohistochemistry (IHC) | IHC : 1:250-1:1000 |
| Immunofluorescence (IF)/ICC | IF/ICC : 1:500-1:2000 |
| Flow Cytometry (FC) (INTRA) | FC (INTRA) : 0.25 ug per 10^6 cells in a 100 µl suspension |
| It is recommended that this reagent should be titrated in each testing system to obtain optimal results. | |
| Sample-dependent, Check data in validation data gallery. | |
产品信息
83901-5-RR targets VPRBP in WB, IHC, IF/ICC, FC (Intra), ELISA applications and shows reactivity with human, mouse, rat samples.
| 经测试应用 | WB, IHC, IF/ICC, FC (Intra), ELISA Application Description |
| 经测试反应性 | human, mouse, rat |
| 免疫原 |
CatNo: Ag2184 Product name: Recombinant human VPRBP protein Source: e coli.-derived, PGEX-4T Tag: GST Domain: 707-1058 aa of BC022792 Sequence: WSQPLSALWGMKSVFDMKHSFTEDHYVEFSKHSQDRVIGTKGDIAHIYDIQTGNKLLTLFNPDLANNYKRNCATFNPTDDLVLNDGVLWDVRSAQAIHKFDKFNMNISGVFHPNGLEVIINTEIWDLRTFHLLHTVPALDQCRVVFNHTGTVMYGAMLQADDEDDLMEERMKSPFGSSFRTFNATDYKPIATIDVKRNIFDLCTDTKDCYLAVIENQGSMDALNMDTVCRLYEVGRQRLAEDEDEEEDQEEEEQEEEDDDEDDDDTDDLDELDTDQLLEAELEEDDNNENAGEDGDNDFSPSDEELANLLEEGEDGEDEDSDADEEVELILGDTDSSDNSDLEDDIILSLNE 种属同源性预测 |
| 宿主/亚型 | Rabbit / IgG |
| 抗体类别 | Recombinant |
| 产品类型 | Antibody |
| 全称 | Vpr (HIV-1) binding protein |
| 别名 | 241028B4, DCAF1, DDB1- and CUL4-associated factor 1, EC:2.7.11.1, HIV 1 Vpr binding protein |
| 计算分子量 | 1506 aa, 169 kDa |
| 观测分子量 | 169 kDa |
| GenBank蛋白编号 | BC022792 |
| 基因名称 | VPRBP |
| Gene ID (NCBI) | 9730 |
| RRID | AB_3671483 |
| 偶联类型 | Unconjugated |
| 形式 | Liquid |
| 纯化方式 | Protein A purfication |
| UNIPROT ID | Q9Y4B6 |
| 储存缓冲液 | PBS with 0.02% sodium azide and 50% glycerol, pH 7.3. |
| 储存条件 | Store at -20°C. Stable for one year after shipment. Aliquoting is unnecessary for -20oC storage. |
背景介绍
VprBP was first identified as a protein that can interact with HIV-1 viral protein R (PMID: 11223251). It is a component of the CUL4A-RBX1-DDB1-VprBP/DCAF1 E3 ubiquitin-protein ligase complex that could interact with HIV-1 virus Vpr protein and HIV-2 virus Vpx protein (PMID: 18332868; 17314515; 18606781). VprBP is a 1,507 amino acid protein that contains conserved domains, including YXXY repeats, the Lis homology motif, and WD40 repeats. Through binding to Vpr, VprBP allows Vpr to modulate the catalytic activity of the CUL4-DDB1 complex, which in turn leads to the induction of G2 phase arrest in the virus-infected cells (PMID: 17630831). Recently it has been reported that VprBP is able to regulate the p53-induced transcription and apoptotic pathway (PMID: 22184063).
实验方案
| Product Specific Protocols | |
|---|---|
| IF protocol for VPRBP antibody 83901-5-RR | Download protocol |
| IHC protocol for VPRBP antibody 83901-5-RR | Download protocol |
| WB protocol for VPRBP antibody 83901-5-RR | Download protocol |
| Standard Protocols | |
|---|---|
| Click here to view our Standard Protocols |